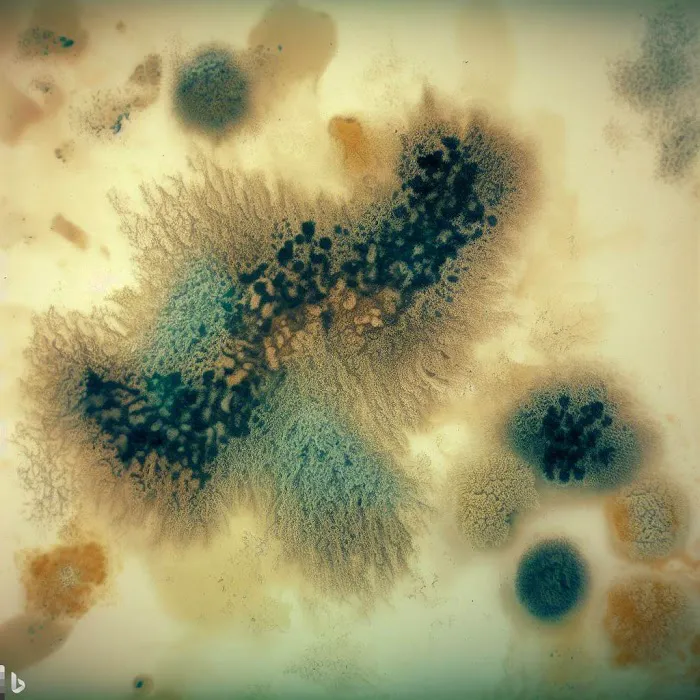
Steemaster Mold Removal & Remediation Palm Bay FL Picture 8

Steemaster Mold Removal & Remediation Palm Bay FL Photos

Steemaster Mold Removal & Remediation Palm Bay FL Introduce
Steemaster Mold Removal & Remediation Palm Bay FL: Specializing in Healthy Homes and Clean Air
Introduction / Overview
In Florida, the phrase "out of sight, out of mind" is a dangerous rule to live by, especially when it comes to moisture and humidity. That damp, musty smell you might ignore can often be the sign of a hidden problem that requires specialized attention. For homeowners and business managers across Brevard County, **Steemaster Mold Removal & Remediation Palm Bay FL** is the go-to expert specializing in identifying, containing, and permanently removing mold and the underlying water damage that causes it.
While often categorized as a **Water damage restoration service**, Steemaster focuses its expertise squarely on the crucial follow-up: dealing with mold. They understand that where there's water intrusion—whether from a forgotten leak, condensation, or storm damage—mold is almost guaranteed in Florida’s climate. Their service model is built around a rapid, transparent, and highly specialized process, ensuring that the air you breathe is clean and your property is structurally sound.
As one customer near Turkey Creek quickly discovered when a "damp basement fume" turned out to be **Black Mold Removal** behind furniture, mold can hide anywhere. Steemaster’s commitment to coming **same-day** for a full **Mold inspection** and clearly explaining the process sets them apart. They don't just tackle the surface issue; they trace the mold back to the source of the water damage, address the structural concerns, and ensure the entire area is sealed, cleaned, and tested for air quality afterward.
Their work is not simply about aesthetics; it is fundamentally about creating a healthier living and working environment. By offering services like **Air Quality Testing** and **Prevention Services**, they provide a comprehensive solution that protects your property investment and your family’s health from the long-term effects of mold contamination. When dealing with something as serious as mold, a dedicated specialist like Steemaster is often the safest and most effective choice.
Location and Accessibility
Steemaster Mold Removal & Remediation is conveniently located in Palm Bay, giving them easy access to serve homes and businesses throughout Brevard County and the surrounding areas. Their centralized location allows for the efficient dispatch of teams for those critical **Emergency Services** when a mold issue is discovered.
Their main address is:
3200 Dixie Hwy NE, Palm Bay, FL 32905, USA
Understanding the necessity of accessibility for all their clients, the Steemaster facility is equipped to be welcoming and accommodating. Their location includes a **Wheelchair accessible entrance** and a **Wheelchair accessible parking lot**, ensuring comfortable access for anyone needing to visit their administrative or consultation offices.
Services Offered
Steemaster Mold Removal & Remediation focuses its services on providing a complete, scientific, and thorough solution for mold and the associated moisture damage. Their expertise covers the full spectrum of mold-related needs, from initial detection to final prevention.
Their specialized professional services include:
- **Emergency Services:** Providing rapid response when water damage leads to an immediate mold threat.
- **Mold Inspection:** Thorough on-site assessment to detect hidden mold and determine the extent of **Mold spread**.
- **Mold Testing:** Professional **Air Quality Testing** and sample analysis to scientifically identify mold types and concentration levels.
- **Mold Remediation:** The complete process of isolating, cleaning, treating, and removing mold, including handling severe cases of **Black Mold Removal**.
- **Water Damage Mitigation and Removal:** Focused effort on stopping the moisture source and removing mold caused by water intrusion (**Water damage-related mold removal**).
- **Mold Damage Repair:** Repairing affected structural materials post-remediation, ensuring the property is left clean, fresh, and mold-free.
- **Prevention Services:** Implementing measures and offering guidance to prevent future mold growth, addressing high-risk areas common in Florida structures.
- **Mold Mitigation and Assessment:** Detailed planning and execution of the cleanup process, including the use of specialized containment and air scrubbing equipment.
Features / Highlights
Steemaster Mold Removal & Remediation sets a high bar for specialized services in the Palm Bay area by focusing on both technical excellence and a high-level, clear communication with their clients—a critical factor when dealing with health-related issues like mold.
Key features and highlights include:
- **Dedicated Mold Specialization:** Unlike general contractors who handle mold as a secondary service, Steemaster focuses exclusively on mold and water-related mold issues, making them highly experienced in Florida’s specific microbial challenges.
- **Emergency Same-Day Response:** Their ability to come **same-day** for inspection and mitigation when mold is discovered is a crucial feature, preventing the mold from spreading and further contaminating the indoor air.
- **Scientific Verification:** They utilize **Air Quality Testing** and **Mold Testing** to not only identify the problem but also to confirm that the remediation process was successful and the environment is safe post-cleanup.
- **Transparent and Respectful Communication:** Customer testimonials repeatedly highlight the team's ability to "explain everything clearly" and avoid "talking down" to clients, building trust during a stressful and sensitive time.
- **Focus on Prevention:** Beyond cleanup, they offer **Prevention Services** and trace the mold back to its **Water damage** source, providing a long-term solution rather than a temporary fix.
- **Budget-Friendly Cleanup:** Demonstrating a commitment to accessible service, with one happy customer noting it was "budget-friendly mold cleanup we could swing," proving professional remediation doesn't have to be prohibitively expensive.
- **Accessibility for All:** Offering both a **Wheelchair accessible entrance** and **Wheelchair accessible parking lot** at their facility.
Contact Information
If you suspect mold or require professional remediation services in the Palm Bay area, prompt contact is recommended to prevent further spread and protect indoor air quality. Use the details below to reach Steemaster Mold Removal & Remediation.
**Address:**
3200 Dixie Hwy NE, Palm Bay, FL 32905, USA
**Phone (Primary Contact/Emergency):**
(321) 366-6032
**Mobile Phone (Direct Line/Emergency):**
+1 321-366-6032
What is Worth Choosing
When dealing with mold in Florida, you need certainty, not guesswork. What is worth choosing about **Steemaster Mold Removal & Remediation Palm Bay FL** is their singular focus on mold as a specialist. In a state where general humidity and moisture can make mold an overwhelming problem, trusting a company whose entire business is built around **Mold Remediation** and **Air Quality Testing** provides maximum confidence.
Their quick response, including **Emergency Services** and same-day inspection, is invaluable for Florida residents, as mold can double in severity within days. They understand the difference between surface mold and structural colonization, implementing necessary steps like containment walls and air scrubbers to execute a proper cleanup and protect the rest of your property.
The highly positive customer feedback underscores their commitment to honesty and efficacy—a company that not only solves the problem quickly but also makes the complex issue of remediation **budget-friendly** and transparent. Choosing Steemaster means securing specialized expertise that ensures the job is done right the first time, protecting your property from the dangers of **Black Mold Removal** and guaranteeing a clean, fresh, and breathable environment for your Florida home or business.
Steemaster Mold Removal & Remediation Palm Bay FL Services
Water Damage Restoration Service
- Mold inspection
Mold inspection is a process conducted by a professional mold inspector or home inspector. During the inspection, the expert visually examines the house to identify any mold growth or moisture-related issues. They assess the damages caused by water, leaks, or any other moisture problems.
- Water damage-related mold removal
Provide water damage restoration services to address the source of moisture that contributes to mold growth.
- Air Quality Testing
Offer air quality testing services to determine the quality of the air in a property, and to identify potential health hazards, including mold spores.
- Black Mold Removal
Black mold refers to a specific species of mold that has a dark green or black appearance. It is important to address black mold promptly as it can be potentially hazardous, especially for individuals with allergies or asthma. Black mold removal involves specialized techniques and equipment.
- Emergency Services
Offer emergency mold removal and remediation services for customers who require immediate assistance.
- Mold Damage Repair
Mold damage repair refers to the restoration and repair work conducted after mold removal. Mold growth can cause damage to materials such as walls, ceilings, flooring, and personal belongings. Mold damage repair involves repairing or replacing affected materials, ensuring proper ventilation.
- Mold Mitigation and Assessment
Mold mitigation focuses on reducing or preventing mold growth in a property. It involves identifying and addressing the underlying causes of mold, such as moisture problems or inadequate ventilation. Mold assessment involves evaluating the mold risk in a property and providing recommendations.
- Mold Remediation
Mold remediation involves the process of cleaning up and removing mold from an affected area. After a mold inspection, a remediation plan is developed by the experts. This plan outlines the steps and strategies to safely and effectively remove the mold.
- Mold Testing
Mold testing involves analyzing air or surface samples to determine the type and concentration of mold present in a specific area. During testing, a mold inspector collects samples that are then sent to a mold testing laboratory. The results provide valuable information about the mold species.
- Prevention Services
Provide preventative services to help customers prevent mold growth in their homes or businesses, such as humidity control and proper ventilation.
Steemaster Mold Removal & Remediation Palm Bay FL Details
Accessibility
- Wheelchair accessible entrance
- Wheelchair accessible parking lot
Steemaster Mold Removal & Remediation Palm Bay FL Location
Steemaster Mold Removal & Remediation Palm Bay FL
3200 Dixie Hwy NE, Palm Bay, FL 32905, USA
Steemaster Mold Removal & Remediation Palm Bay FL Reviews
black moldscrubberssmellmold remediationwalls
★ 5★ 4★ 3★ 2★ 1At first I blamed the smell in our housing near Turkey Creek on sweaty gear that never saw the wash. Plot twist: it was black mold behind the couch. Awesome.We called Steemaster Mold Removal & Remediation Palm Bay and honestly, I was bracing for a scam. Instead, they came same-day, did a full mold inspection, spotted the water damage and mold spread, and explained everything without talking down to us. They put up containment walls, ran the air scrubbers, and knocked out the mold cleanup way faster than I thought. Even the air feels cleaner — like actual breathable air, not damp basement fumes.Mold remediation isn’t exactly a fun expense, but it was budget-friendly mold cleanup we could swing. If you’ve got hidden mold behind walls or furniture, don’t wait. Call them. I already taped their card on the fridge next to the pizza coupons.
Sep 04, 2025 · Izan Leroy autoI contacted Steemaster Mold Removal & Remediation FL for mold removal in Palm Bay after noticing mold in my laundry room. Their team was fantastic from start to finish — professional, on time, and very thorough. They explained everything clearly and made sure the job was done right. After their service, my laundry room looks clean, fresh, and completely mold-free. I’m really happy with how it turned out and would definitely recommend Steemaster to anyone dealing with mold issues in Palm Bay!
Aug 13, 2025 · Parker CrookTurns out my roommate’s “seasonal allergies” weren’t allergies at all — it was black mold creeping behind the laundry wall at our Palm Bay place near Turkey Creek. The sneezing marathon finally made me search for emergency mold removal at 2am, and Steemaster Mold Remediation popped up.They actually answered the phone, sent a certified mold inspector the same day, and ran an air quality test that confirmed a toxic mold issue. The tech explained the entire mold remediation and affordable mold cleanup process clearly, and even gave me a detailed mold report I could hand straight to the landlord.The team set up containment, did professional mold cleanup, and used scrubbers to fix the air. By the weekend, the swampy smell and constant sneezing were gone.Insurance-covered mold work is a joke, but these guys made the rest simple. Definitely keeping their number in case more mold damage shows up behind the walls.
Aug 22, 2025 · Jesse Edward
More Water Damage Restoration Near Me
Bio LLC5.0 (42 reviews)1212 Vista Oaks Cir NE, Palm Bay, FL 32905, USA
Stanley Steemer4.0 (1806 reviews)3400 Dairy Rd, West Melbourne, FL 32904, USA
Palm Bay Mold Removal5.0 (20 reviews)948 Canada St NE, Palm Bay, FL 32905, USA
Brevard Mold Inspection & Removal4.0 (37 reviews)7617 Ellis Rd #152, West Melbourne, FL 32904, USA
Emergency Mold Removal LLC.5.0 (22 reviews)1068 Hutchins St SE, Palm Bay, FL 32909, USA
ORC Services, Inc.4.0 (124 reviews)401 Sebastian Blvd Suite A Ste A, Sebastian, FL 32958, USA
Innovative Restoration & Cleaning4.0 (22 reviews)5575 U.S. Rte 1 #8, Vero Beach, FL 32967, USA
SERVPRO of Vero Beach4.0 (104 reviews)4360 U.S. Rte 1, Vero Beach, FL 32967, USA
ORC Services, Inc - Vero Beach5.0 (8 reviews)2501 27th Ave A10, Vero Beach, FL 32960, USA
United Water Restoration of Vero Beach5.0 (1 reviews)601 21st St Ste. 30 0, Vero Beach, FL 32960, USA
ServiceMaster by Glenn's4.0 (65 reviews)1505 10th Ave, Vero Beach, FL 32960, USA
Navigate Restoration5.0 (35 reviews)1375 U.S. Rte 1 Suite 1, Vero Beach, FL 32960, USA
Categories
Top Visited Sites
PureOne Services Connecticut4.0 (13 reviews)
First Response Restoration of Stamford5.0 (27 reviews)
Restoration Specialist5.0 (51 reviews)
Brock Restoration4.0 (108 reviews)
Flood Department4.0 (52 reviews)
Los Angeles Water Damage Restoration and Mold Inspections5.0 (1 reviews)Top Water Damage Restoration Searches
Trending Damage Repair Guides Posts
How Long Does Water Damage Restoration Take? A Homeowner’s Guide
How to Handle Water Damage From Roof Leaks Effectively
How to Protect Your Home from Water Damage in a Flood Zone – Essential Tips
What Are the Key Signs of Water Damage in Your Home?
How to Protect Your Home from Plumbing-Related Water Damage
How to Handle Water Damage From Basement Floods | Tips for Clean-up and Prevention
